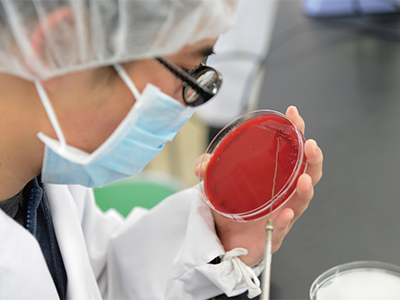
Junior-College-of-Health-and-Hygienic-Sciences Junior-College-of-Health-and-Hygienic-Sciences

About Kitasato University
- トップ
- About
- About Kitasato University and The Kitasato Institute
- About Kitasato University
President's Message

SUNAZUKA Toshiaki
President, Kitasato University
President, Kitasato University
Pursuing Kitasato's Unique Approach to Learning and Passing on Our Academic Tradition to the Next Generation
"With the development of our organization, we would like to follow the footsteps of the Pasteur Institute and contribute to the nation and society by applying our research on microorganisms not only to medicine and hygiene, but also to other fields such as agriculture, fisheries, industry, etc."
More than 110 years since Dr. KITASATO Shibasaburo, the founder of Kitasato University, described the future of Kitasato at the opening ceremony of the Kitasato Institute in 1914, Kitasato University is literally "university of life sciences" with nine faculties, eight graduate schools, three hospitals, two vocational schools, and one research institute, and is the only university in Japan that brings together various academic fields such as agriculture, oceanography, engineering, in addition to medicine. As we are currently engaged in various inter-departmental collaborations such as team medical practice and agricultural-medical collaboration, I, as President, would like to further accelerate these collaborations and promote cross- departmental learning in an interdisciplinary environment, which is unique to Kitasato. In the meantime, Kitasato University's identity still lies in "research.” In his remarks at the opening ceremony of the Kitasato Institute, Dr. KITASATO Shibasaburo, the founder of Kitasato University, also said, "I want to contribute to the nation and society through research" and "The main axis (of the Institute) is the research department." Moreover, the "spirit of practical science" of contributing to society through research results is the academic tradition of Kitasato University, which has been passed down from its founder, Dr. KITASATO Shibasaburo, to our mentor, Dr. ŌMURA Satoshi, who was awarded the Nobel Prize in Physiology or Medicine. I believe that it is my mission as president to pass on this academic tradition to the next generation.
In the modern society in which we live, the environment surrounding us is changing at an unprecedented speed due to global environmental changes, developments in science and technology, and the impact of emerging infectious diseases. It is in these times that we will remember our founder, Dr. KITASATO Shibasaburo, and under his spirit of pioneering, thankfulness, wisdom and practice, and tenacity, which he always taught his students, Kitasato University will further promote and develop education and research, and contribute to society with a spirit of practical science.
More than 110 years since Dr. KITASATO Shibasaburo, the founder of Kitasato University, described the future of Kitasato at the opening ceremony of the Kitasato Institute in 1914, Kitasato University is literally "university of life sciences" with nine faculties, eight graduate schools, three hospitals, two vocational schools, and one research institute, and is the only university in Japan that brings together various academic fields such as agriculture, oceanography, engineering, in addition to medicine. As we are currently engaged in various inter-departmental collaborations such as team medical practice and agricultural-medical collaboration, I, as President, would like to further accelerate these collaborations and promote cross- departmental learning in an interdisciplinary environment, which is unique to Kitasato. In the meantime, Kitasato University's identity still lies in "research.” In his remarks at the opening ceremony of the Kitasato Institute, Dr. KITASATO Shibasaburo, the founder of Kitasato University, also said, "I want to contribute to the nation and society through research" and "The main axis (of the Institute) is the research department." Moreover, the "spirit of practical science" of contributing to society through research results is the academic tradition of Kitasato University, which has been passed down from its founder, Dr. KITASATO Shibasaburo, to our mentor, Dr. ŌMURA Satoshi, who was awarded the Nobel Prize in Physiology or Medicine. I believe that it is my mission as president to pass on this academic tradition to the next generation.
In the modern society in which we live, the environment surrounding us is changing at an unprecedented speed due to global environmental changes, developments in science and technology, and the impact of emerging infectious diseases. It is in these times that we will remember our founder, Dr. KITASATO Shibasaburo, and under his spirit of pioneering, thankfulness, wisdom and practice, and tenacity, which he always taught his students, Kitasato University will further promote and develop education and research, and contribute to society with a spirit of practical science.
The Apogee of Life Sciences and Medicine
Kitasato University proactively responds to the urgent need for Life Science research that is cuttingedge, interdisciplinary and comprehensive, as well as the need for the training of leaders in this research. The University strives to be a scientific educational institution that can play a leading role as it continues to work toward a higher level of excellence in the fields of education, research and medicine. Firmly grounded in basic research and ranging over many fields, this organic network of knowledge is supported by the undergraduate schools, the College of Liberal Arts and Sciences, the graduate schools, the research institutes and affiliated hospitals.
Via Four Specialized Fields,
A Comprehensive Approach to Life Sciences
1. Human life and health-related fields
2. Plant and animal and environment-related fields
3. Fields that conduct basic research in Life Sciences
4. Fields that identify future issues through data analysis
Our Four Guiding Principles
The Spirit of Pioneering
Use your ingenuity and creativity to be a pioneer in the world of science.
The Spirit of Thankfulness
Be thankful to the people and society that fostered you, and repay your debt with your contribution to society.
The Spirit of Wisdom and Practice
Put your knowledge and skills into practice for the benefit of society.
The Spirit of Tenacity
Tackle whatever challenge you may face with unwavering determination.
The Philosophy of Kitasato University
With profound respect for the sanctity of life, our purpose is to contribute to society by dedicating ourselves to the quest for truth through the application of practical science.
University's Data
Number of Academic Staff(78KB)
Number of Students(83KB)
Placement of Graduates(107KB)
Advancement to Graduate Schools(102KB)
Number of Students(83KB)
Placement of Graduates(107KB)
Advancement to Graduate Schools(102KB)
Formal Emblem

The school emblem of Kitasato University is marked by the character. A pair of drumsticks at the center of the emblem represents the tetanus bacillus, which commemorates the founder Shibasaburo Kitasato's success in pure culture of the bacillus and the establishment of the serum therapy.
Students Emblem

The student's emblem is modeled on the shape of a heart—the center of the human body. The right atrium (upper left) represents the tetanus bacillus, which Shibasaburo Kitasaso studied. The left atrium is colored differently for the individual collages and their initials are placed inside. Prussian blue is the university's color. This emblem was designed by one of the first-generation students.
Education and Research Activities
As an educational and technical institution at the cutting edge of the Life Sciences, Kitasato University is highly regarded for its educational and research activities. Many of its projects have received grants from the Ministry of Education, Culture, Sports, Science and Technology, other government ministries, industry and elsewhere.